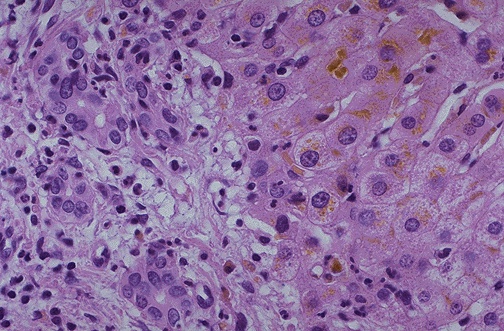

| In this case of extrahepatic biliary tract obstruction, the total bilirubin was 8.0 mg/dL with direct bilirubin of 7.2 mg/dL. The alkaline phosphatase was also elevated. The liver here shows prominent intracellular as well as canalicular cholestasis. |
![]() |